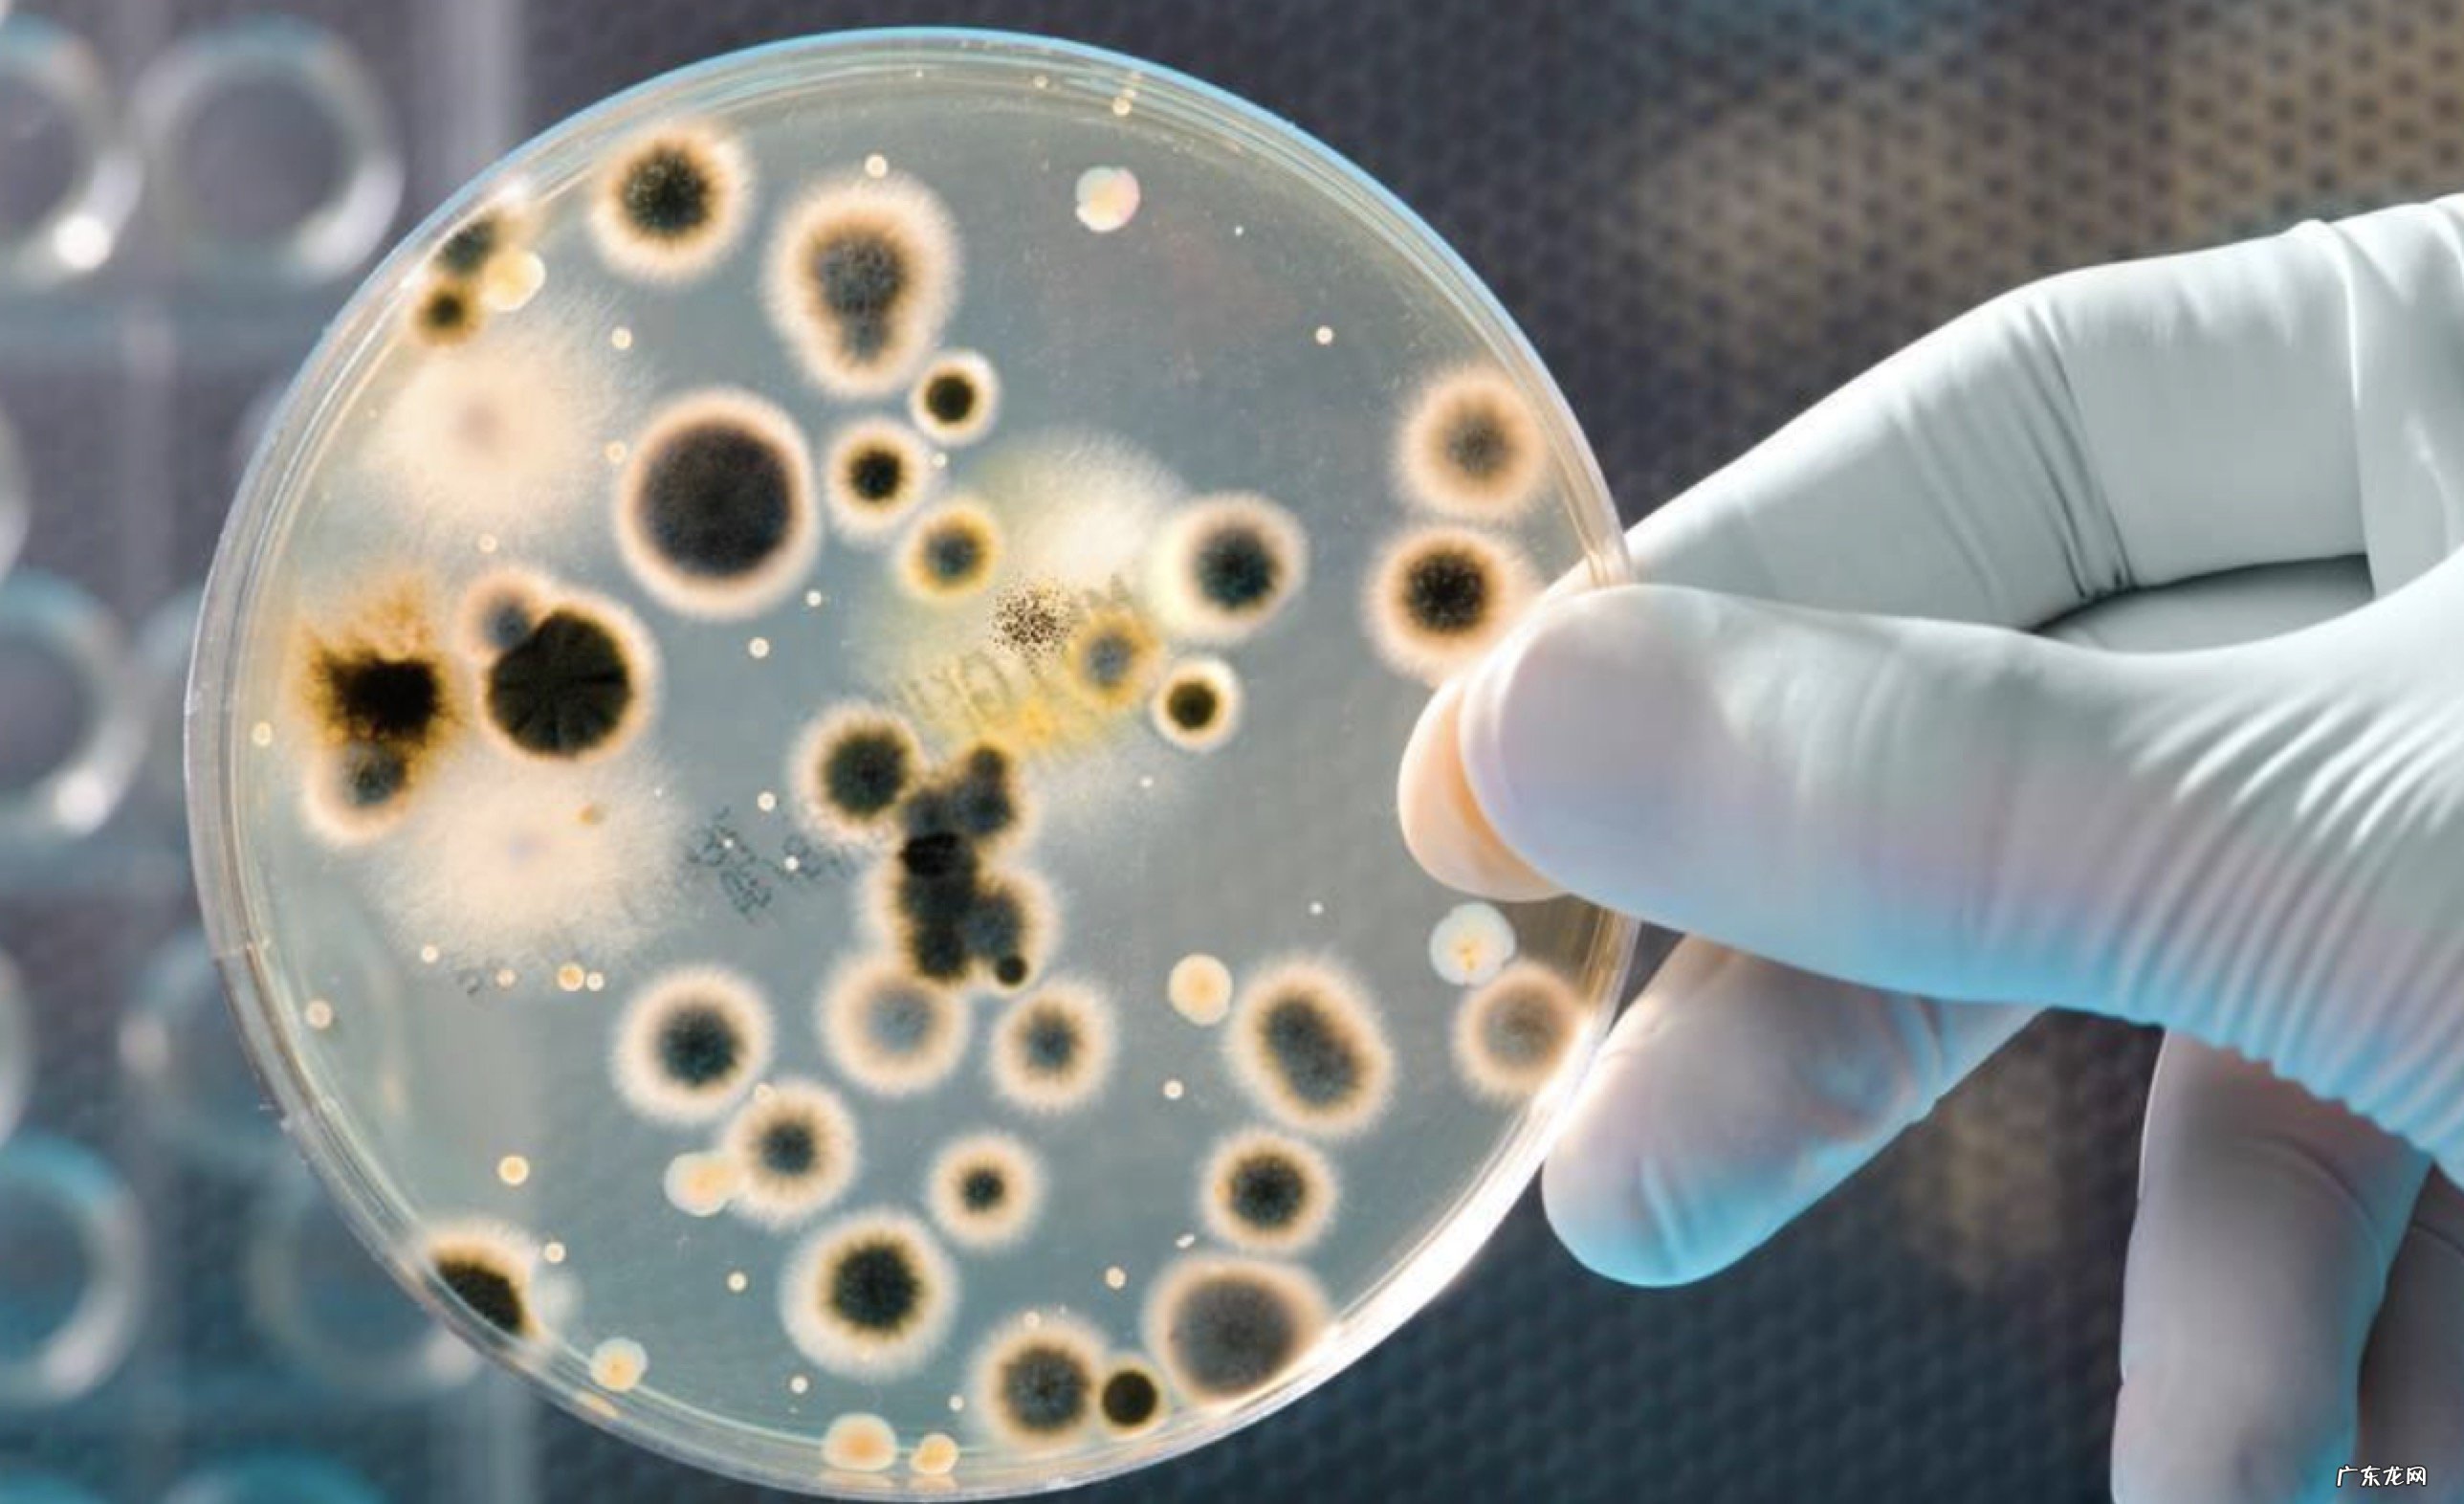
细菌有哪些合成代谢产物与致病性和医药有关的各是哪些

简述细菌的合成代谢产物及其在医学上的意义 。细菌合成代谢产物有热原质、毒素和侵袭性酶、色素、抗生素、细菌素以及维生素 。

文章插图

文章插图
1 , 热原质:细菌合成的一种注入人体或动物体内能引起发热反应的物质也称致热原 。产生热原质的细菌大多是革兰阴性菌;

文章插图
文章插图
2 , 毒素和侵袭性酶:内毒素是革兰阴性菌细胞壁的脂多糖;外毒素是革兰阳性菌及少数革兰阴性菌合成并分泌到菌体外的毒性蛋白质 。侵袭性酶是细菌合成的能损伤机体组织促使细菌在机体内生存和扩散的一类酶;
3 , 色素:水溶性色素能弥散到培养基或周围组织脂溶性色素不溶于水故仅菌落显色;
4 , 抗生素:某些微生物代谢过程中产生的一类能杀死其他微生物或肿瘤细胞的物质 。大多数抗生素由放线菌和真菌产生仅有多粘菌素、杆菌肽等少数抗生素由细菌产生;
5 , 细菌素:某些细菌产生的一类抗菌蛋白但抗菌范围狭窄仅对近缘关系密切的细菌有杀伤作用 。主要用于细菌分型和流行病学调查;
6 , 维生素:有些细菌自身能合成维生素 。如人肠道的大肠埃希菌合成维生素B和维生素K能供人体吸收利用 。
扩展资料:
细菌的影响和危害:
【细菌有哪些合成代谢产物与致病性和医药有关的各是哪些】细菌对环境 , 人类和动物既有用处又有危害 。一些细菌成为病原体 , 导致了破伤风、伤寒、肺炎、梅毒、霍乱和肺结核 。在植物中 , 细菌导致叶斑病、火疫病和萎蔫 。感染方式包括接触、空气传播、食物、水和带菌微生物 。病原体可以用抗菌素处理 , 抗菌素分为杀菌型和抑菌型 。
细菌通常与酵母菌及其他种类的真菌一起用于酦酵食物 , 例如在醋的传统制造过程中 , 就是利用空气中的醋酸菌(Acetobacter)使酒转变成醋 。其他利用细菌制造的食品还有奶酪、泡菜、酱油、醋、酒、优格等 。细菌也能够分泌多种抗生素 , 例如链霉素即是由链霉菌(Steptomyces)所分泌的 。
细菌能降解多种有机化合物的能力也常被用来清除污染 , 称做生物复育(bioremediation) 。举例来说 , 科学家利用嗜甲烷菌(methanotroph)来分解美国佐zhi亚州的三氯乙烯和四氯乙烯污染 。
细菌也对人类活动有很大的影响 。例如奶酪及优格的制作、部分抗生素的制造、废水的处理等 , 都与细菌有关 。在生物科技领域中 , 细菌也有着广泛的运用 。
参考资料来源:百度百科-细菌
产物及意义:
(1)毒素和侵袭性酶是细菌重要的致病因素 。
(2)热原质是细菌重要的致病因素 。
(3)色素有助于细菌的鉴别 。
(4)抗生素抑制或杀灭其他微生物 。
(5)细菌素在细菌分型和流行病学调查上具有一定的价值 。
细菌是许多疾病的病原体 , 包括肺结核、淋病、炭疽病、梅毒、鼠疫、砂眼等疾病都是由细菌所引发 。然而 , 人类也时常利用细菌 , 例如乳酪及酸奶和酒酿的制作、部分抗生素的制造、废水的处理等 , 都与细菌有关 。在生物科技领域中 , 细菌有也着广泛的运用 。
- 寿命“长”的女人,有哪些个“共性”
- 淘宝直播达人带货榜维度有哪些?排榜范围介绍
- 点淘春日妆容活动怎么参与?活动有何奖励?
- 速卖通5天上网率是什么意思?考核有什么标准?
- 淘宝老店有什么好处?怎么做起来?
- 天猫国际支付方式安全吗?不足之处有哪些?
- 请教折叠自行车有什么缺点?
- 淘宝怎么看别人店铺数据?有哪些方法?
- 万相台影响搜索吗?有哪些玩法?
- 夏天短裤有哪些类型 夏天短裤怎么挑选
特别声明:本站内容均来自网友提供或互联网,仅供参考,请勿用于商业和其他非法用途。如果侵犯了您的权益请与我们联系,我们将在24小时内删除。
